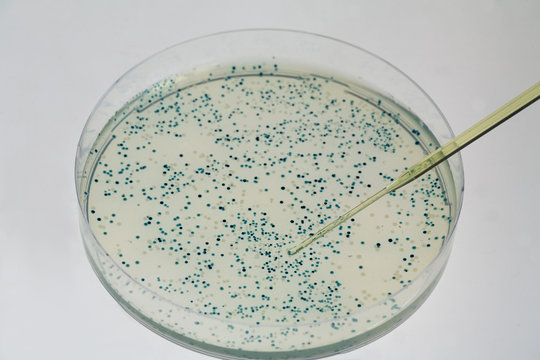
Blau-weiss-Selektion

Versione di prova gratuita: ottieni 10 immagini stock, più strumenti di modifica AI
Versione di prova gratuita: ottieni 10 immagini stock, più strumenti di modifica AI
Aggiunti nuovi filtri
Ordina per
2 risultati per alpha-komplementation in tutto
Prova anche:
alpha-komplementation in immagini
Scegliete l’area geografica
La selezione dell’area geografica può cambiare la lingua e il contenuto delle promozioni disponibili nel sito Web di Adobe Stock.
Nord America
Sud America
- Venezuela
- Algeria - English
- Armenia - English
- Azerbaijan - English
- Bahrain - English
- Belgium - English
- Belgique - Français
- België - Nederlands
- Česká republika
- Croatia - English
- Cyprus - English
- Danmark
- Georgia - English
- Deutschland
- Eesti
- Egypt - English
- España
- France
- Greece - English
- Iceland - English
- Ireland
Europa, Medio Oriente e Africa
- Israel - English
- Italia
- Jordan - English
- Казахстан
- Kenya - English
- Kuwait - English
- Киргизия
- Latvija
- Lebanon - English
- Lietuva
- Luxembourg - Deutsch
- Luxembourg - English
- Luxembourg - Français
- Mauritius - English
- Moldova - English
- Hungary - English
- Malta - English
- Morocco - English
- Nederland
- Nigeria
- Norge
- Oman - English